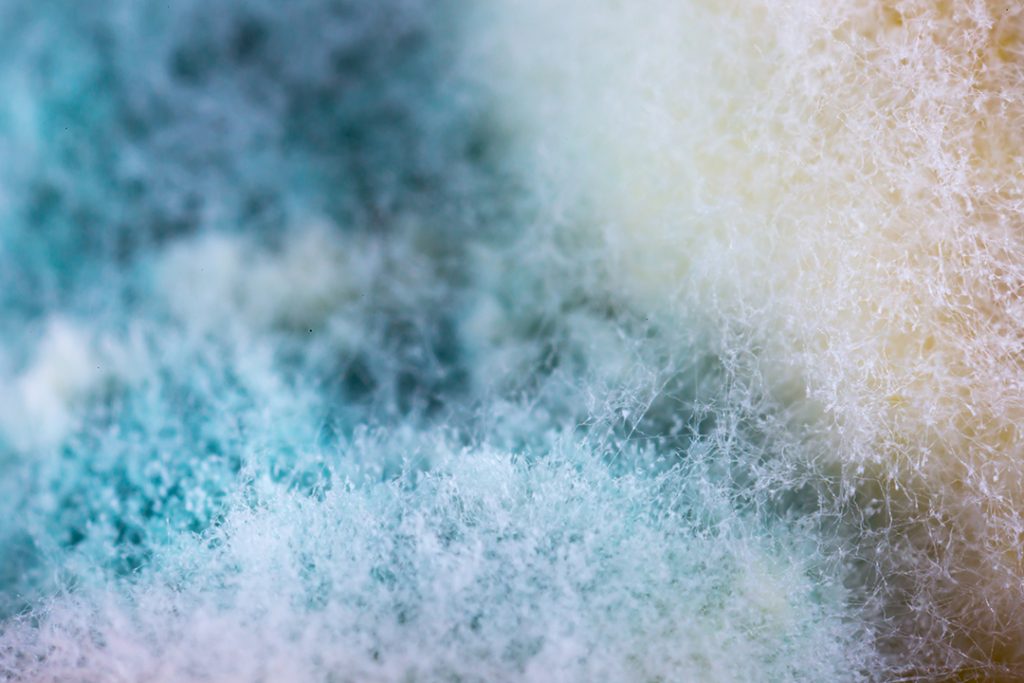

Vi jobbar för att göra hela Luleå cirkulärt


Våra öppettider
Planerar du ett besök till någon av våra återvinningscentraler eller second hand-butiker? Här hittar du alla våra öppettider. Välkommen!
Se våra öppettider
Hitta närmaste återvinningsstation
I Luleå finns 50 återvinningsstationer som ska göra vardagssorteringen enklare för oss Luleåbor. Har du koll på din närmsta station?
ÅtervinningsstationerTa hjälp av vår digitala sorteringsguide
När avfallet hamnar på rätt ställe kan mer återbrukas och återvinnas och vi spar på jordens resurser. Hitta din närmaste återvinningscentral eller återvinningsstation.
När har jag tömning?
Ange din adress för att se när Lumire tömmer ditt avfall eller din brunn. Kom även ihåg att ställa kärlen med öppningen mot gatan och med ett mellanrum på minst en halvmeter.
Nyheter
- Uddebo blir först i norra Sverige med Revaq-certifiering
 Lumire har beslutat att Revaq-certifiera Uddebo reningsverk – ett viktigt steg i arbetet för ett hållbart och cirkulärt kretslopp. När certifieringen är klar blir Uddebo …
Lumire har beslutat att Revaq-certifiera Uddebo reningsverk – ett viktigt steg i arbetet för ett hållbart och cirkulärt kretslopp. När certifieringen är klar blir Uddebo … - Hedersomnämnande i Kranvattentävlingen
 Under dagens deltävling på Ebeneser kulturcentrum gick Boden och Älvsbyn vidare till riksfinalen i Kranvattentävlingen. Kranvattnet från Luleå fick ett hedersomnämnande av juryn. – Det …
Under dagens deltävling på Ebeneser kulturcentrum gick Boden och Älvsbyn vidare till riksfinalen i Kranvattentävlingen. Kranvattnet från Luleå fick ett hedersomnämnande av juryn. – Det … - Förslag till justerad VA-avgift
 Inför 2026 föreslås en justering av bruknings- och anläggningsavgiften för vatten och avlopp i Luleå. Taxehöjningen ska bland annat finansiera de omfattande satsningar som gjorts …
Inför 2026 föreslås en justering av bruknings- och anläggningsavgiften för vatten och avlopp i Luleå. Taxehöjningen ska bland annat finansiera de omfattande satsningar som gjorts …
Läs mer i vårt nyhetsarkiv